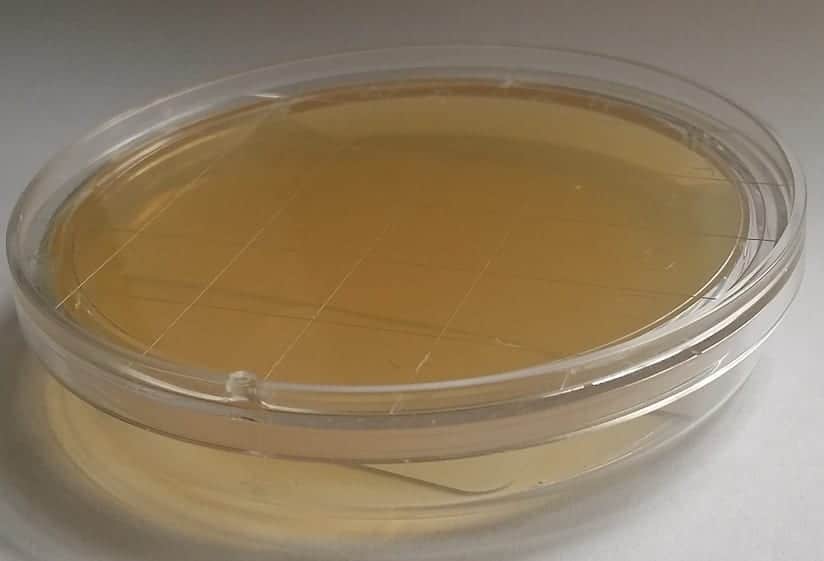

Tällä hometesti V8 elatusaineella voidaan selvittää syitä kiinteistön sisäilmaongelmiin. Puutteellinen ilmanvaihto, kosteusvaurio ja esimerkiksi mikrobikasvustoissa viihtyvät ötökät voivat aiheuttaa pysyviä terveyshaittoja. Terveyden kannalta homeet aiheuttavat ärsytysoireita silmissä ja limakalvoilla, väsymystä, päänsärkyä ja infektiosairauksia, kuten korvatulehduksia ja poskiontelontulehduksia. Pahimmillaan seuraus voi olla keuhkoastma tai homepölykeuhko. Terveysoireiden lisäksi homekasvuston ja sädesienen voi tunnistaa maakellarimaisesta hajusta, vaatteisiin tarttuva hajusta, pistävästä hajusta, makeasta hajusta. Vaikka normaaleissa olosuhteissa jokaisessa tilassa on tietty määrä bakteereita, on hyvä selvittää aika ajoin, jos määrä on terveydelle haitallista ja vaatii toimenpiteitä.
Testin tekeminen
- Näyte otetaan rakennuksen sisäpinnasta yhdestä kohdasta yhdellä painalluksella jonka jälkeen purkki suljetaan. Näytteessä kasvavat kaikki näytteenottopinnoilla olleet itiöt. Homeitiöitä löytyy yleensä aina pinnoilta, jotka ovat kosketuksissa sisä- tai ulkoilman kanssa.
- Testin tulos selviää 4-8 päivän kuluttua, mikäli homeitiöipesäkkeiden määrä ylittää suositusarvot on syytä tehdä jatkotutkimuksia.
- Näyte voidaan toimittaa laboratorioon mikrobien tunnistusta varten kahden viikon sisällä näytteen otosta.
Tarkempaa tietoa kosteusvaurioista löytyy monilta tahoilta, tämän linkin takana sekä alla oleva yhteenveto esimerkiksi.
Kosteusvaurio on yleinen vitsaus suomalaisissa kodeissa. Yleensä syynä on suunnitteluvirhe, huonojen materiaalien käyttö ja huolimaton työ. Toisaalta asunnon liian korkea ilmankosteus voi aiheuttaa homeiden kasvua. Home vaatii kosteutta kasvaakseen. Jos vesi ja kosteus pääsevät paikkoihin joista ne eivät pääse pois eivätkä kuivu tai tuuletu voi seurauksena alkaa kasvamaan hometta ja sieniä.
Kosteusvaurion havaitsee yleensä silmämääräisesti. Maalit, muovimatot ja tapetit irtoilevat tai parketit tummuvat. Hopehohtoisten siivetön sokeritoukka elää asuntojen kosteissa tiloissa viemäreiden lähistöllä. Se on kaikkiruokainen ja syö myös hometta. Siksi niiden runsas esiintyminen voi olla merkki kosteusvauriosta. Homeen tuntee usein ummehtuneena maakellarimaisena hajuna. Asukkailla voi alkaa ilmestymään homeen aiheuttamaa oireilua.
Homevaurion tutkimuksilla pyritään selvittämään nimenomaan vaurion syy, sekä laajuus, vakavuus ja aiheuttaja. Korjaukset eivät onnistu ellei tiedetä mistä kosteus ja homehtuminen johtuvat ja löydetä vian syytä.
Pelkkien vaurioiden korjaaminen ilman niihin johtaneiden syiden poistamista johtaa ongelman nopeaan uusiutumiseen. Vauriokohtia ei pidä vain peittää vaan kosteusvaurion ja sen synnyttämän homekasvun syy on poistettava. Korjaa kosteus- tai homevauriot välittömästi. Korjauksen laiminlyönti kostautuu ja moninkertaistaa ongelman.
Hometesti V8 voi tarvittaessa laajentaa täyteen laboratorio tutkimukseen, tuotteen löydät tästä.

Arviot
Tuotearvioita ei vielä ole.